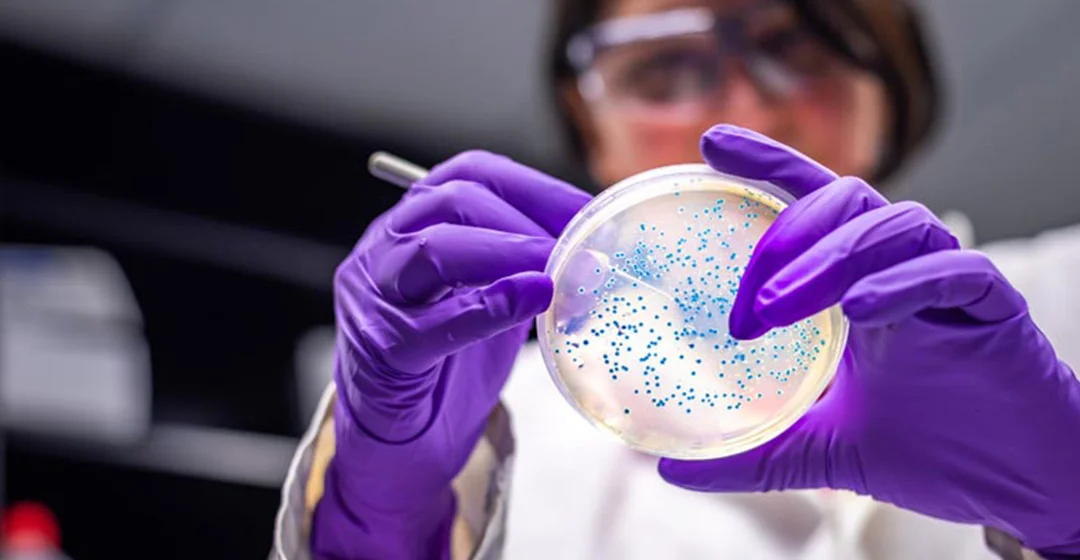
IEE-research-collaboration-1080x560

Surviving the split: the impact of R&D alliance breakups
Breaking up is hard to do, but when it’s a knowledge alliance between life science firms, splitting up has various effects on knowledge acquisition and innovation that are not entirely adverse.
So say Esade’s Jan Hohberger and Heidi Kruger (Esade) together with Paul Almeida (McDonough School of Business), who analysed R&D alliances in the life science industry over a 13-year period to identify the impact that premature termination had on knowledge acquisition.